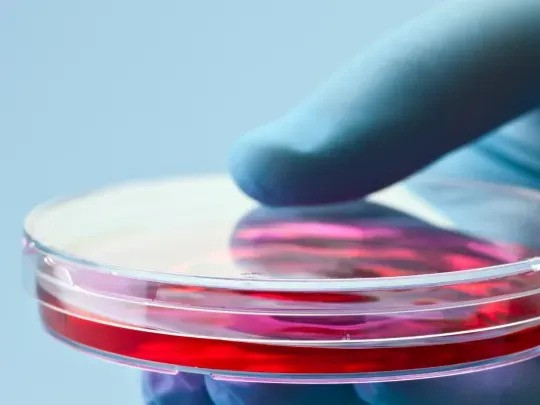

Key Considerations for Selecting a Stem Cell Doctor
Clearwater, United States – February 28, 2026 / NexGenEsis Stem Cell – Clearwater /
When it comes to selecting a stem cell doctor, patients face a critical decision that can significantly impact their health and well-being. Stem cell therapy has emerged as a promising treatment option for various conditions, but the effectiveness of this treatment largely depends on the expertise of the physician administering it. Therefore, it is essential for patients to carefully evaluate several key factors before making their choice.
One of the first considerations should be the doctor’s qualifications. Patients should look for a stem cell doctor who is board-certified in a relevant medical specialty, such as hematology, oncology, or regenerative medicine. Board certification indicates that the physician has undergone rigorous training and has met specific standards of knowledge and skill in their field. Additionally, patients should inquire about the doctor’s educational background, including where they completed their medical degree and any additional training in stem cell therapy. A well-qualified doctor will be transparent about their credentials and willing to provide documentation upon request.
Experience is another crucial factor when choosing a stem cell doctor. Patients should seek out a physician who has extensive experience in administering stem cell treatments. This includes not only the number of procedures performed but also the types of conditions treated. A doctor with a diverse range of experience is more likely to be familiar with the nuances of different cases and can tailor treatment plans to meet individual patient needs. Patients may also want to ask about the outcomes of previous treatments, as this can provide insight into the doctor’s success rate and overall effectiveness.
In addition to qualifications and experience, patients should consider the treatment methods employed by the stem cell doctor. There are various approaches to stem cell therapy, including the use of autologous stem cells (derived from the patient’s own body) and allogeneic stem cells (derived from a donor). Each method has its own set of advantages and potential risks, and the choice of method should be based on the patient’s specific condition and overall health. A reputable stem cell doctor will take the time to explain the different options available and help patients make informed decisions about their treatment.
Another important aspect to evaluate is the clinic’s approach to patient care. A good stem cell doctor will prioritize patient safety and comfort throughout the treatment process. This includes conducting thorough pre-treatment evaluations to assess the patient’s medical history and current health status. Patients should feel comfortable discussing their concerns and asking questions about the treatment process. A physician who fosters open communication and takes the time to address patient inquiries is more likely to provide a positive treatment experience.
Furthermore, patients should consider the clinic’s facilities and resources. A well-equipped clinic with advanced technology and a supportive staff can enhance the overall treatment experience. Patients should inquire about the clinic’s accreditation and whether it adheres to established safety and quality standards. This can provide reassurance that the clinic is committed to maintaining high levels of care and patient safety.
It is also beneficial for patients to seek out reviews and testimonials from previous patients. Hearing about others’ experiences can provide valuable insights into the doctor’s approach and the effectiveness of the treatments offered. Patients can look for online reviews, testimonials on the clinic’s website, or even ask the doctor for references. A stem cell doctor with a strong reputation and positive feedback from patients is likely to be a reliable choice.
In addition to these considerations, patients should also be aware of the financial aspects of stem cell therapy. The cost of treatment can vary significantly depending on the type of therapy, the clinic, and the specific condition being treated. Patients should inquire about the pricing structure and whether the clinic offers payment plans or financing options. It is also important to check whether the treatment is covered by insurance, as this can greatly affect the overall cost.
Finally, patients should trust their instincts when choosing a stem cell doctor. The relationship between a patient and their physician is built on trust and mutual respect. If a patient feels uncomfortable or uncertain about a particular doctor or clinic, it is perfectly acceptable to seek out other options. The right stem cell doctor should inspire confidence and provide a sense of reassurance throughout the treatment journey.
In conclusion, selecting a stem cell doctor is a significant decision that requires careful consideration of various factors. Patients should prioritize qualifications, experience, treatment methods, and the overall approach to patient care. By taking the time to research and evaluate potential doctors, patients can ensure they receive the best possible care for their needs. Ultimately, the right stem cell doctor can make a meaningful difference in a patient’s health and quality of life.
Learn more on https://www.nexgenesishealthcare.com/nexgenesis-healthcare-locations/clearwater-fl/

Contact Information:
NexGenEsis Stem Cell – Clearwater
501 S Lincoln Ave, Suite 11
Clearwater, FL 33756
United States
Andrew Mcnall
(727) 221-9121
https://nexgenesishealthcare.com